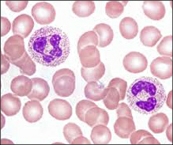

SLR and Compact Cameras










Brunel Microscopes Ltd
Registered in U.K. (England) No: 2060047
find us on youtube, facebook and twitter


The use of standard digital cameras for photomicrography
There are a vast number of digital photography cameras on the market. From the microscope (or indeed the telescope) perspective there are basically two types. Those that can have their lenses removed (SLR and Pancake cameras) and those that cannot (commonly called compact cameras).
Those that can have their lenses removed are easy to fit to microscopes. They are attached via a suitable adapter and a T2 ring to suit the camera make (Canon, Nikon, Olympus etc). In effect the microscope then becomes the lens system for the camera back. The type of adapter needed will vary according to the microscope model but are basically of two types those that need an eyepiece (photoeyepiece) to be added and those that have a photoeyepiece already built in.

Digital Microscope Cameras









Olympus TG Microscope Adapter Elements

Brunel Olympus TG Adapter

Algae and human blood sample images

Obviously when we look down a microscope the final image is the result of the magnifying power of the objective being used and the magnifying power of the eyepiece. The SLR camera back therefore needs its own eyepiece as well.
To keep down costs the eyepiece of the microscope can be used but the results will be disappointing because as the image emerges from the eyepiece and travels through the depth of the camera back to its chip it diverges quite rapidly which results in a reduction in the field of view and some distortion of the final image. Far better results are obtained by using a photoeyepiece for the camera. These are specifically designed to give a flat image showing the same field of view as seen down the microscope normally. Typically a x2.5 photoeyepiece will give you the same image results when compared to looking through the microscope with x10 eyepieces. This will add to the cost and of course as with all optics there are the standard quality and superior quality units which is reflected in the price. As a general rule of thumb the quality of the photoeyepiece should reflect the quality of the microscope optics themselves, there is no point in using and expensive photoeyepiece in a system attached to a budget microscope. The most sensible options are shown in the accessories for each the microscopes we sell. Our universal adapter has the photoeyepiece already built in and will fit directly into the trinocular tube of a microscope and via a T2 ring to an SLR camera back, however it is relatively expensive and more suited to our more expensive microscopes.
The accessories for each of our microscopes will show the most sensible adapter, photoeyepiece and T2 ring for an SLR camera
If you need further assistance then please call us on 01249 462655




Olympus TG Microscope Adapter Attached
Compact Cameras
The vast majority of compact cameras are not suitable for attaching to a microscope. A small number of models will have a screw thread on the end of the lens which means they could be attached using step rings to a camera adapter, but most of these will have a zoom mechanism that will not optically merge with the optics of a microscope. There are so many of these on the market with new models arriving almost daily that it is not practical to offer the very short list of those that may be suitable. If you have a compact camera and do not wish to buy something more suitable then using your mobile phone with our Phonelink is probably the better option.
However (and there is always a ‘however’) Olympus TG camera owners can attach their cameras to microscopes with our TG adapter with relative ease. We do not sell Olympus TG cameras themselves just the adapters to fit, but we understand they are very well regarded as robust units with excellent capability. So if you are an Olympus TG (current models TG6 and TG7) owner this is what you would need to attach your camera to one of our microscopes -
This is possible because the Olympus TG series has a lens external link that allows the Mcoplus adapter to attach to the camera and we have developed an adapter that links to the Mcoplus and our advanced Unilink that has a high end photoeyepiece as an integral part.
Price £70.00 + vat




